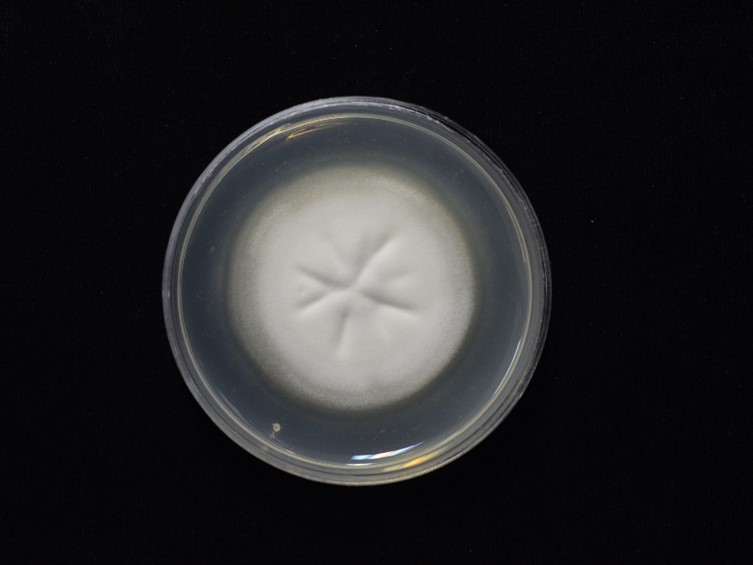

Holotype:
THAILAND, Tak Province, Umphang District, Umphang Wildlife Sanctuary, Thi Lo Su Waterfall nature trail, 24 Nov. 2010, A. Khonsanit, K. Sansatchanon, K. Tasanathai, P. Srikitikulchai & W. Noisripoom, holotype BBH30086, ex-type living culture BCC45148.
Habitat:
Upper side of dicotyledonous leaves
Host:
Adult of Lemyra sp. (Erebidae)
Description:
 Specimens found on adult of Lemyra sp. (Erebidae: Lepidoptera), on the upper side of dicotyledonous leaves and the leaf litter, thin whitish mycelium covering the host body.
Specimens found on adult of Lemyra sp. (Erebidae: Lepidoptera), on the upper side of dicotyledonous leaves and the leaf litter, thin whitish mycelium covering the host body.  Perithecia superficial, crowded at the apex of synnemata, ovoid, light olive brown, 360−550
× 200−260 µm.
Perithecia superficial, crowded at the apex of synnemata, ovoid, light olive brown, 360−550
× 200−260 µm.  Asci cylindrical, hyaline, 400−470 × 5 µm. Ascospores filiform, multi-septate, breaking into part-spores, hyaline. Part-spores cylindrical, hyaline, 3–11 × 0.5−1 µm.
Asci cylindrical, hyaline, 400−470 × 5 µm. Ascospores filiform, multi-septate, breaking into part-spores, hyaline. Part-spores cylindrical, hyaline, 3–11 × 0.5−1 µm.
Culture characteristics:
Colony on PDA flat, closely appressed to the agar surface, velvety, entire margin, attaining a diam of 36–
41 mm in 20 d, white, pale yellow, pale greenish yellow. Conidia and reproductive structures are not observed on both media after 30 d of incubation at 25 °C.
Colony on PDA flat, closely appressed to the agar surface, velvety, entire margin, attaining a diam of 36–
41 mm in 20 d, white, pale yellow, pale greenish yellow. Conidia and reproductive structures are not observed on both media after 30 d of incubation at 25 °C.
Reference:
A. Khonsanit, D. Thanakitpipattana, S. Mongkolsamrit, et al. (2024). A phylogenetic assessment of Akanthomyces sensu lato in Cordycipitaceae (Hypocreales, Sordariomycetes): introduction of new genera, and the resurrection of Lecanicillium. Fungal Systematics and Evolution14:271–305.
DOI: https://doi.org/10.3114/fuse.2024.14.17Species |
Strain |
Compound |
Pubchem CID |
Biological activity |
Reference |
|---|
|
Strain |
- |
|---|---|
| BCC 45148T | - |
| BCC 76537 | - |